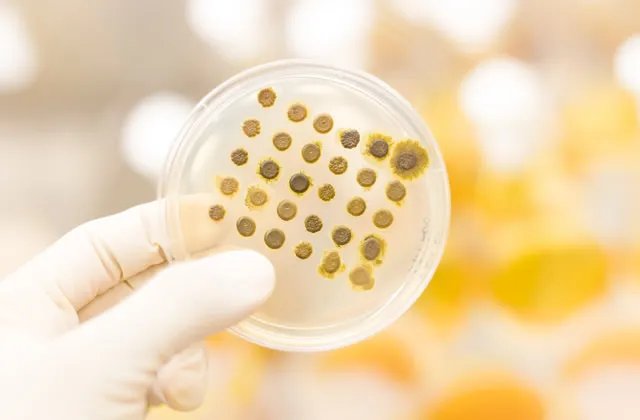
实验室耗材是什么意思 实验室耗材属于什么行业

实验室耗材是什么意思 实验室耗材属于什么行业
的有关信息介绍如下:一、实验室耗材是什么意思
实验室耗材是专业院校或医疗单位的检验检测部门、第三方的独立检验检测机构以及其他的实验室开展实验工作的常用物品,主要是指完成检验、实验项目过程中的标本采集装置、标本盛放装置以及实现标本检测的提取、分杯、比色等工作的装置。
其本质的特点就是一次性使用,主要为一次性塑料制品和一次性玻璃制品等(目前基本以塑料制品为主)。
该图片由注册用户"浅尝不止—"提供,版权声明反馈
二、实验室耗材属于什么行业
不同的实验室耗材行业归属不同,如生物实验室一次性耗材行业属于生命科学服务行业的细分行业。
生物实验室一次性塑料耗材主要用于细胞培养和收获、生物实验移液、溶液过滤和分离、贮存等。高端一次性耗材对实验结果有直接影响。国内一些领先的耗材供应商在生产工艺与产品质量方面已经和国际同类产品相当,部分参数指标甚至更优。但是受制于生产规模和品牌影响力等因素,国内市场占比很小。随着国内生厂商的逐步壮大,销售渠道的进一步扩展,其产品质优价廉的竞争优势将逐步推进一次性塑料耗材的国产替代。



